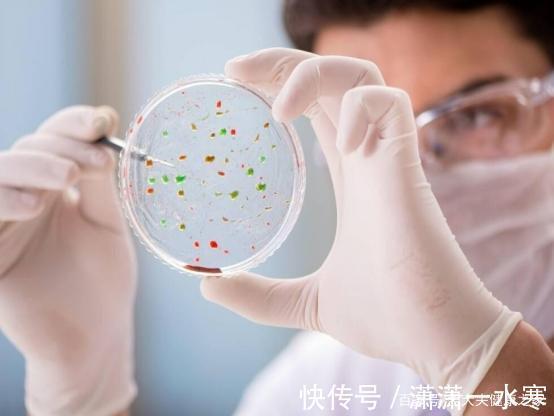
高血脂|降脂必看，得了高血脂症和动脉粥样硬化，该怎么办

高血脂|降脂必看,得了高血脂症和动脉粥样硬化,该怎么办
血脂症和动脉粥样硬化是非常常见的疾病,给人们的生活带来了极大的麻烦。尤其是中老年朋友,一旦患上这两种疾病,就会引起身体其他并发症的出现,且治疗起来非常的麻烦。因此,必须要加强日常生活的管理和预防。那么平时我们应该怎么去预防?除了要保证良好的生活起居之外,必须要在饮食方面加强控制。少吃油腻的食物,减少胆固醇的摄入,多吃新鲜的水果和蔬菜,都有利于降低血脂症和动脉粥样硬化的发生。

文章插图
一、引起高血脂和动脉粥样硬化的主要原因1.不健康的饮食习惯不健康的饮食习惯会导致人体血液浓度增大,胆固醇升高,从而造成血管堵塞或血管壁损伤引起高血压、高血脂和糖尿病;长时间不积极治疗的话,就会导致脑卒中的发生。另外,血脂升高还会引起动脉粥样硬化,使得心血管疾病发生的概率增大,给患者身体健康造成极大的隐患。另外,胆固醇升高还会引起身体其他疾病。比如现垂体功能减退,甲状腺功能亢进,以及甲减、甲亢等等。
文章插图
其次,胆固醇升高还会导致许多慢性并发症,比如糖尿病和高血压,尤其是原发性高血压,患者需要长期服药,控制血压水平。因此患者必须要尽量的少吃刺激性,含胆固醇高的食物,平时应多喝水,多吃新鲜的水果和蔬菜,有助于促进消化功能,增强个人抵抗力。2.不健康的生活习惯胆固醇和血压升高都会引起高血脂和动脉粥样硬化,从而造成其他疾病的产生。其中,熬夜是最主要的因素。由于现代社会人们的生活节奏变快,许多人在繁忙的工作压力下,使得入睡的时间越来越晚,多数人在感到身体十分疲惫的情况下才去休息。久而久之容易积劳成疾,使人体的免疫力降低,使疾病趁虚而入,如心血管疾病和肾病。心血管疾病和肾病治疗时间久,难以彻底根除,给患者的心理和家庭经济带来严重负担。此外,即使是治愈到一个理想的程度,有的患者可能会伴有后遗症。

文章插图
3.缺乏运动运动的好处有很多,经常运动有助于血液循环,提升个人代谢能力。如果一个人缺乏运动,就会影响生理功能,长时间不坚持运动,必然会导致疾病的出现。如肥胖症,肥胖症的出现很大程度上是因为不运动导致的。人每天都必须要摄入一定的食物,来维持身体功能正常运作。生活中许多事物都含有高热量和胆固醇,这些物质进入人体需要分解;运动是最有效的方法,运动能降低胆固醇的堆积,避免引起其他心血管疾病的发生。

文章插图
另外,长期坚持合理的运动,能最大程度上缓解身体不适症状,提高个人免疫力。其次,许多上班族有久坐,不运动的表现,经常久坐会影响肠胃健康,会出现消化不良,食欲不振,腹痛、腹泻的症状,甚至会出现慢性胃溃疡。

文章插图
4.疾病个人疾病也是引起高血脂和动脉粥样硬化的一个原因。人血管中的血脂浓度过高,会给血管壁造成一定压力,胆固醇在血管中堆积到一定的程度,则会引起患者出现头晕,头疼,胸闷,心慌心悸等等。其次,经常便秘的人身体长期处于亚健康的状态,加之生活作息不规律的影响,会直接导致心血管疾病的产生。另外,消化肠道功能差的人会出现血管功能下降,血液循环不畅,久而久之高血脂和动脉粥样硬化会出现。
- 橙子是高血脂的发物吗?滋养血管,牢记“三吃、四不吃”
- 抗衰|人到中年,3种食物换着吃,排毒抗衰,降压降脂,增强体质
- 清理血管|高血脂的“劲敌”被找到,并非山楂,若你爱吃,血脂或乖乖降下来
- 血管|高血脂的“特效药”被发现,每天吃一点,血管通畅,血脂轻松降
- 血管垃圾|不想血管被堵死, 这些食物要常吃,清理血管垃圾,降压又降脂
- 免疫|乳腺癌患者必看!这些常用药要慎服丨“乳”此治疗
- 甘油|“降脂冠军”被发现,煤矿老板甘油三酯从5.2降到1.6,众人直呼:学到了!
- 来自陕西的李永(化名)是个煤老板|“降脂冠军”被发现,煤矿老板甘油三酯从5.2降到1.6,众人直呼:学到了!
- 冠心病|高血脂“害怕”3件事,你若能坚持,血管一天比一天干净!
- 每天坚持吃洋葱,时间长了,能不能降血脂?高血脂人群早点了解
